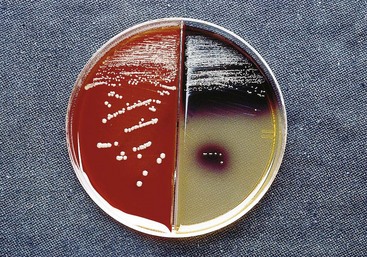
image
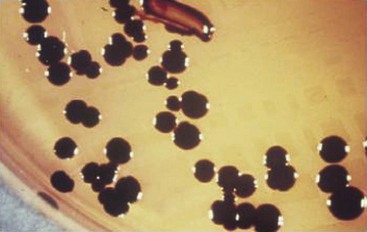
image

38 Anaerobic Gram-Negative Bacteria
Most clinically important anaerobic gram-negative rods were originally classified in the genus Bacteroides. Although many of these organisms were reclassified, Bacteroides fragilis remains the most important member of this group.
1. What is the most important virulence factor of B. fragilis?
Answers
1. The polysaccharide capsule protects the bacteria from phagocytosis and can stimulate abscess formation.
2. Infections caused by B. fragilis are characterized by abscess formation. Although this organism has been implicated in infections of the lungs and brain, intraabdominal and skin and soft-tissue infections are the most common.
3. Metronidazole, carbapenems, and combinations of β-lactams and β-lactamase inhibitors.
The most important gram-negative anaerobes that colonize the human upper respiratory, gastrointestinal, and genitourinary tracts are the rods in the genera Bacteroides, Fusobacterium, Parabacteroides, Porphyromonas, and Prevotella and the cocci in the genus Veillonella (Table 38-1). Anaerobes are the predominant bacteria at each of these sites, outnumbering aerobic bacteria 10- to 1000-fold. The diversity of species is also great, with as many as 500 different species of bacteria estimated to colonize the periodontal pocket, many of which are anaerobes. Despite the abundance and diversity of these bacteria, most infections are caused by relatively few species (Table 38-2).
Table 38-1 Important Gram-Negative Anaerobes
| Organism | Historical Derivation |
|---|---|
| Bacteroides | bacter, staff or rod; idus, shape (rod shaped) |
| B. fragilis | fragilis, fragile (related to fragile colonies) |
| B. thetaiotaomicron | thetaiotaomicron, from the Greek letters theta, iota, omicron |
| Fusobacterium | fusus, a spindle; bakterion, a small rod (a small, spindle-shaped rod) |
| F. nucleatum | nucleatum, having a kernel or nucleated (refers to the “flecked” or ground-glass appearance of colonies) |
| F. necrophorum | necros, dead; phorum, bearing (necrosis producing) |
| Parabacteroides | para, related to (related to Bacteroides) |
| P. distasonis | distasonis, Distaso (named after A. Distaso, a Romanian bacteriologist) |
| Porphyromonas | porphyreos, purple; monas, unit (pigmented rods) |
| P. asaccharolytica | a, not; sacchar, sugar; lyticus, able to loosen (not digesting sugar; asaccharolytic) |
| P. gingivalis | gingivalis, of the gums |
| Prevotella | Prevotella, named after the French microbiologist A.R. Prevot, a pioneer in anaerobic microbiology |
| P. intermedia | intermedia, intermediate (formerly classified as one of three subspecies of Bacteroides melaninogenicus: subsp. melaninogenicus, subsp. intermedius, and subsp. asaccharolyticus) |
| P. melaninogenica | melas, black; genicus, producing (producing a black color or colony) |
| P. bivia | bivius, having two ways (pertaining to the saccharolytic and proteolytic activities of the species) |
| P. disiens | disiens, going in two ways (saccharolytic and proteolytic activities) |
| Veillonella parvula | Veillonella, named after A. Veillon, the French bacteriologist who isolated the type species; parvula, very small (refers to the size of the cocci—not the bacteriologist!) |
Table 38-2 Predominant Anaerobic Gram-Negative Bacteria Responsible for Human Disease
| Infection | Bacteria |
|---|---|
| Head and neck | Bacteroides ureolyticus |
| Fusobacterium nucleatum | |
| Fusobacterium necrophorum | |
| Porphyromonas asaccharolytica | |
| Porphyromonas gingivalis | |
| Prevotella intermedia | |
| Prevotella melaninogenica | |
| Veillonella parvula | |
| Intraabdominal | Bacteroides fragilis |
| Bacteroides thetaiotaomicron | |
| P. melaninogenica | |
| Gynecologic | B. fragilis |
| Prevotella bivia | |
| Prevotella disiens | |
| Skin and soft tissue | B. fragilis |
| Bacteremia | B. fragilis |
| B. thetaiotaomicron | |
| Fusobacterium spp. |
Physiology and Structure
The genus Bacteroides is composed of more than 90 species and subspecies, with Bacteroides fragilis the most important member of this genus. A characteristic common to the most species in the genus Bacteroides is that their growth is stimulated by 20% bile. Bacteroides species are pleomorphic in size and shape and resemble a mixed population of organisms in a casually examined Gram stain (Figure 38-1). Other anaerobic gram-negative rods can be very small (e.g., Porphyromonas, Prevotella) or elongated (e.g., Fusobacterium; Figure 38-2). Most gram-negative anaerobes respond weakly to Gram stain, so stained specimens must be carefully examined. Although Bacteroides species grow rapidly in culture, the other anaerobic gram-negative rods are fastidious, and cultures may have to be incubated for 3 days or longer before the bacteria can be detected.

Figure 38-1 Bacteroides fragilis. Organisms appear as faintly staining, pleomorphic, gram-negative rods.

Figure 38-2 Fusobacterium nucleatum. Organisms are thin, faintly staining, and elongated with tapered ends (e.g., fusiform).
Bacteroides have a typical gram-negative cell wall structure, which can be surrounded by a polysaccharide capsule. A major component of the cell wall is a surface lipopolysaccharide (LPS). In contrast to the LPS molecules in Fusobacterium and the aerobic gram-negative rods, the Bacteroides LPS has little or no endotoxin activity. This is because the lipid A component of LPS lacks phosphate groups on the glucosamine residues, and the number of fatty acids linked to the amino sugars is reduced; both factors are correlated with the loss of pyrogenic activity.
The anaerobic gram-negative cocci are rarely isolated in clinical specimens except when present as contaminants. Members of the genus Veillonella are the predominant anaerobes in the oropharynx, but they represent less than 1% of all anaerobes isolated in clinical specimens. The other anaerobic cocci are rarely isolated.
Pathogenesis and Immunity
Despite the variety of anaerobic species that colonize the human body, relatively few are responsible for causing disease. For example, Parabacteroides distasonis and Bacteroides thetaiotaomicron are the predominant anaerobic gram-negative rods found in the gastrointestinal tract; however, the majority of intraabdominal infections are associated with B. fragilis, an organism that is a minor member of the gastrointestinal flora. The enhanced virulence of this and other pathogenic anaerobes is attributed to a variety of virulence factors that facilitate adherence of the organisms to host tissues, protection from the host immune response, and tissue destruction.
Adhesins
B. fragilis and Prevotella melaninogenica strains can adhere to peritoneal surfaces more effectively than other anaerobes because their surface is covered with a polysaccharide capsule. B. fragilis, other Bacteroides species, and Porphyromonas gingivalis can adhere to epithelial cells and extracellular molecules (e.g., fibrinogen, fibronectin, lactoferrin) by means of fimbriae. The fimbriae of P. gingivalis are also important for inducing expression of proinflammatory cytokines, such as tumor necrosis factor-α and interleukin-1β (IL-1β).
Protection against Phagocytosis
The polysaccharide capsule of these organisms is antiphagocytic, similar to other bacterial capsules. In addition, the short-chain fatty acids (e.g., succinic acid) produced during anaerobic metabolism inhibit phagocytosis and intracellular killing. Finally, proteases are produced by some Porphyromonas and Prevotella species that degrade immunoglobulins.
Protection against Oxygen Toxicity
In general, anaerobes capable of causing disease can tolerate exposure to oxygen. Catalase and superoxide dismutase, which inactivate hydrogen peroxide and the superoxide free radicals (O2−), respectively, are present in many pathogenic strains.
Tissue Destruction
A variety of cytotoxic enzymes have been associated with gram-negative anaerobes. Many of these enzymes are found in both virulent and avirulent isolates, so the role they play in disease is unclear.
Toxin Production
Strains of enterotoxigenic B. fragilis that cause diarrheal disease produce a heat-labile zinc metalloprotease toxin (B. fragilis toxin). This toxin causes morphologic changes of the intestinal epithelium via F-actin rearrangement, with the resultant stimulation of chloride secretion and fluid loss. The enterotoxin also induces IL-8 secretion by intestinal epithelial cells, thus contributing to inflammatory damage to the epithelium.
Epidemiology
As already stated, anaerobic gram-negative cocci and rods colonize the human body in large numbers. Their numerous important functions at these sites include stabilizing the resident bacterial flora, preventing colonization by pathogenic organisms from exogenous sources, and aiding in the digestion of food. These normal protective organisms produce disease when they move from their endogenous homes to normally sterile sites (i.e., the same as described for gram-positive, non–spore-forming anaerobes in Chapter 37). Thus the organisms in the resident flora are able to spread by trauma or disease from the normally colonized mucosal surfaces to sterile tissues or fluids.
As expected, these endogenous infections are characterized by the presence of a polymicrobial mixture of organisms. It is important to realize, however, that the mixture of organisms appear on healthy mucosal surfaces differs from the mixture in diseased tissues. Studies of the microbial population, or microbiome, of healthy mucosal surfaces show a complex mixture of many species of bacteria. In the disease state, the mixture changes to less diversity (i.e., fewer species are represented) and predominance of the most clinically significant organisms. For example, B. fragilis is commonly associated with pleuropulmonary, intraabdominal, and genital infections. However, the organism constitutes less than 1% of the colonic flora and is rarely isolated from the oropharynx or genital tract of healthy people unless highly selective techniques are used.
Clinical Diseases
Respiratory Tract Infections
Nearly half of the chronic infections of the sinuses and ears, and virtually all periodontal infections, involve mixtures of gram-negative anaerobes, with Prevotella, Porphyromonas, Fusobacterium, and non-fragilis Bacteroides the most commonly isolated. Anaerobes are less commonly associated with infections of the lower respiratory tract unless there is a history of aspiration of oral secretions.
Brain Abscess
Anaerobic infections of the brain are typically associated with a history of chronic sinusitis or otitis. Such history is confirmed by radiologic evidence of direct extension into the brain. A less common cause of such infections is bacteremic spread from a pulmonary source. In this case, multiple abscesses are present. The most common anaerobes in these polymicrobial infections are species of Prevotella, Porphyromonas, and Fusobacterium (as well as Peptostreptococcus and other anaerobic and aerobic cocci).
Intraabdominal Infections
Despite the diverse population of bacteria that colonize the gastrointestinal tract, relatively few species are associated with intraabdominal infections. Anaerobes are recovered in virtually all of these infections, with B. fragilis the most common organism (Figure 38-3). Other important anaerobes are B. thetaiotaomicron and P. melaninogenica, as well as the anaerobic and aerobic gram-positive cocci.
Gynecologic Infections
Mixtures of anaerobes are often responsible for causing infections of the female genital tract (e.g., pelvic inflammatory disease, abscesses, endometritis, surgical wound infections). Although a variety of anaerobes can be isolated in patients with these infections, Prevotella bivia and Prevotella disiens are the most important; B. fragilis is commonly responsible for abscess formation.
Skin and Soft-Tissue Infections (Clinical Case 38-1)
Although anaerobic gram-negative bacteria are not part of the normal flora of the skin (in contrast to Peptostreptococcus and Propionibacterium organisms), they can be introduced by a bite or through contamination of a traumatized surface. In some cases, the organisms may simply colonize a wound without producing disease; in other cases, colonization may quickly progress to life-threatening disease, such as myonecrosis (Figure 38-4). B. fragilis is the organism most commonly associated with significant disease.
Clinical Case 38-1
Retroperitoneal Necrotizing Fasciitis
Pryor and associates (Crit Care Med 29:1071–1073, 2001) described an unfortunate patient with a polymicrobic fasciitis. A 38-year-old man with a 10-year history of human immunodeficiency virus infection underwent an uncomplicated hemorrhoidectomy. Over the next 5 days, thigh and buttock pain developed with nausea and vomiting. At the time that the man presented to the hospital, he had a heart rate of 120 beats/min, blood pressure of 120/60 mm Hg, respiratory rate of 22 respirations/min, and temperature of 38.5° C. Physical examination revealed extensive erythema around the surgical site, flank, thighs, and abdominal wall. Gas was observed in the tissues underlying the areas of erythema and extended to his upper chest. At surgery, extensive areas of tissue necrosis and foul-smelling brownish exudates were found. Multiple surgeries to aggressively debride the involved tissues were necessary. Cultures obtained at surgery grew a mixture of aerobic and anaerobic organisms, with Escherichia coli, β-hemolytic streptococci, and Bacteroides fragilis predominating. This clinical case illustrates the potential complications of rectal surgery—aggressive destruction of tissue, polymicrobic etiology with B. fragilis as a prominent organism, and foul-smelling necrotic tissue with gas production.
Bacteremia
Anaerobes were at one time responsible for more than 20% of all clinically significant cases of bacteremia; however, these organisms now cause 3% to 5% of such infections. The reduced incidence of disease is not completely understood but probably can be attributed to the widespread use of broad-spectrum antibiotics. B. fragilis is the anaerobe most commonly isolated in blood cultures.
Laboratory Diagnosis
Microscopy
Microscopic examination of specimens from patients with suspected anaerobic infections can be useful. Although the bacteria may stain faintly and irregularly, the finding of pleomorphic, gram-negative rods can serve as useful preliminary information.
Culture
Specimens should be collected and transported to the laboratory in an oxygen-free system, promptly inoculated onto specific media for the recovery of anaerobes, and incubated in an anaerobic environment. Because most anaerobic infections are endogenous, it is important to collect specimens so that they are not contaminated with the normal bacterial population present on the adjacent mucosal surface. Specimens should also be kept in a moist environment because drying causes significant bacterial loss.
Most Bacteroides grow rapidly and should be detected within 2 days; however, recovery of other gram-negative anaerobes may require longer incubation. In addition, it is sometimes difficult to recover all clinically significant bacteria because of the different organisms present in polymicrobial infections. The use of selective media, such as media supplemented with bile, has facilitated the recovery of most important anaerobes (Figure 38-5). In addition, lysed-blood-enriched media stimulates pigment production in organisms such as Porphyromonas and Prevotella (Figure 38-6).
Figure 38-5 Growth of Bacteroides fragilis on Bacteroides bile-esculin agar. Most aerobic and anaerobic bacteria are inhibited by bile and gentamicin in this medium, whereas the B. fragilis group of organisms is stimulated by bile, resistant to gentamicin, and able to hydrolyze esculin, producing a black precipitate.
Biochemical Identification
Although the identification of gram-negative anaerobes has traditionally been performed by biochemical tests, the proliferation of newly-recognized species has made this approach unreliable. Sequence analysis of species-specific genes (e.g., 16S ribosomal RNA gene) is a reliable but time-consuming and expensive approach. More recently, the proteomic tools (i.e., mass spectrometry for spectral analysis of species-specific protein profiles) have been used for organism identification. Although this technology is primarily restricted to large reference laboratories, it is likely that this will move rapidly into most clinical laboratories.
Treatment, Prevention, and Control
Antibiotic therapy combined with surgical intervention is the main approach for managing serious anaerobic infections. Virtually all members of the B. fragilis group, many Prevotella and Porphyromonas species, and some Fusobacterium isolates produce β-lactamases. This enzyme renders the bacteria resistant to penicillin and many cephalosporins. Antibiotics with the best activity against gram-negative anaerobic rods are metronidazole, carbapenems (e.g., imipenem, meropenem), and β-lactam–β-lactamase inhibitors (e.g., piperacillin-tazobactam). Clindamycin resistance in Bacteroides, which is plasmid mediated, has become more prevalent; an average of 20% to 25% of the isolates in the United States are now resistant.
Because Bacteroides species constitute an important part of the normal microbial flora, and because infections result from the endogenous spread of the organisms, disease is virtually impossible to control. It is important to recognize, however, that disruption of the natural barriers around the mucosal surfaces by diagnostic or surgical procedures can introduce these organisms into normally sterile sites. If the barriers are invaded, prophylactic treatment with antibiotics may be indicated.
A 65-year-old man entered the emergency department of a local hospital. He appeared to be acutely ill, with abdominal tenderness and a temperature of 40° C. The patient was taken to surgery because appendicitis was suspected. A ruptured appendix surrounded by approximately 20 ml of foul-smelling pus was found at laparotomy. The pus was drained and submitted for aerobic and anaerobic bacterial culture analysis. Postoperatively, the patient was started on antibiotic therapy. Gram stain of the specimen revealed a polymicrobial mixture of organisms, and the culture was positive for B. fragilis, Escherichia coli, and Enterococcus faecalis.
1. Which organism or organisms are responsible for causing the abscess formation? What virulence factors are responsible for causing abscess formation?
2. B. fragilis causes infections at what other body sites?
3. What antibiotics should be selected to manage this polymicrobial infection?
4. What other anaerobic gram-negative rods are important causes of human disease?
1. Abscess formation in this clinical situation is most likely caused by B. fragilis. The polysaccharide capsule stimulates leukocyte migration and abscess formation.
2. B. fragilis colonizes the colon in relatively small numbers. However, this organism is highly virulent and has been implicated in diseases in many body sites, including lungs (pulmonary abscess), central nervous system (brain abscess), abdomen (intraabdominal abscess), genitourinary tract (pelvic abscess), gastrointestinal tract (gastroenteritis), cardiovascular system (thrombophlebitis, septicemia), and soft tissues (myonecrosis).
3. Metronidazole is uniformly active against Bacteroides, and carbapenems (e.g., imipenem, meropenem) are active against most strains. E. coli is generally susceptible to the carbapenems and broad-spectrum cephalosporins. Treatment of serious enterococcal infections requires use of a cell wall active antibiotic (e.g., β-lactam, vancomycin) with an aminoglycoside.
4. Other anaerobic gram-negative rods associated with human disease include Prevotella, Porphyromonas, and Fusobacterium.